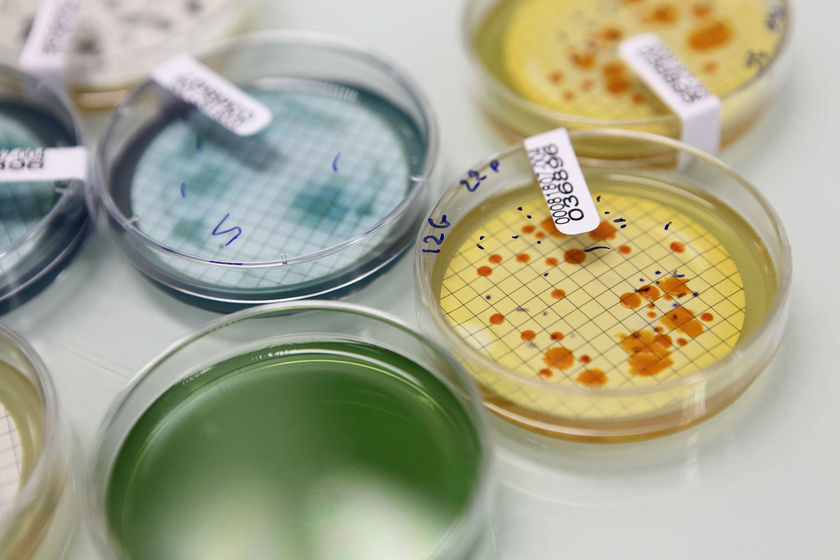
Ostilhoù ha servijoù evit industriezh ar boued

Embregerezhioù ar gumuniezh
Embregerezhioù hag o deus choazet an tolpad-kêrioù ha Bro-Gerne.
War dachenn industriezh ar boued
 War dachenn industriezh ar boued
War dachenn industriezh ar boued
- Cafés Coïc – Krazañ kafe
- Germicopa – Krouiñ gouennoù avaloù-douar nevez
- Entremont – Produiñ boued-laezh
- Lampaulaise de salaison (stroll Turenne Lafayette) – Produiñ charkuterezh
- Meralliance (stroll Thaï Union Frozen, Thailand) – Produiñ pesked mogedet
- Père Dodu (stroll Doux) –Fardañ meuzioù keginet enno kig-yar
- Saupiquet (stroll Bolton, Italia) – Fardañ boued-mir diwar pesked
Ostilhoù ha servijoù evit industriezh ar boued
Ostilhoù ha servijoù evit industriezh ar boued
Ostilhoù ha servijoù evit industriezh ar boued
- Capic – Ijinañ ha sevel ostilhoù evit poazhat hag evit skignañ, evit industriezh ar boued
- Hema Sidel (stroll Barry Wehmiller, US) – Ijinañ ha sevel mekanikoù evit leuniañ gant produioù ha dourennoù
- Krampouz – Ijinañ ha fardañ pilligoù, galfrezerioù, planchas, grilhoù evit an dud a vicher hag an dud all
- Labexia (stroll Carso) – Labourva dielfennañ war dachenn industriezh ar boued
- Labocéa – Labourva dielfennañ ha kontrolliñ e-keñver ar yec’hed
- Lima – Sevel mekanikoù da ziveskañ ar c’hig
Niverel
 Niverel
Niverel
- Appnexus (US) – Savenn bruderezh diouzh ar c’hresk war-eeun
- Cimut – Kreizenn urzhiataerezh ar c’henwarezioù
- Interface Concept – Ijinañ ha sevel reizhiadoù e bourzh evit un implij foran pe gant an arme
- Lacroix Electronics – Ijinañ ha sevel fonksionoù elektronek evit produioù o fratikoù
- Mitel (US) – Pourchas produioù ha diskoulmoù d’an embregerezhioù a-fet brudañ
Energiezhioù an amzer-da-zont
 Energiezhioù an amzer-da-zont
Energiezhioù an amzer-da-zont
- Blue Solutions (stroll Bolloré) – Ijinañ ha fardañ batirioù evit kirri tredan
- Sabella – Ijinañ rodoù-dour evit produiñ tredan
Meur a embregerezh er penn a-raok
 Energiezhioù an amzer-da-zont
Energiezhioù an amzer-da-zont
- Armor-Lux – Produiñ ha gwerzhañ dilhad prest da wiskañ
- Axon Mechatronics – Ijinañ ha sevel kevreerioù, amredoù tredan, elfennoù mekatronek
- Bolloré division Films plastique (stroll Bolloré) – Produiñ filmoù plastik
- Cadiou Industrie – Ijinañ ha fardañ porrastelloù ha skloturioù
- CMA – Sevel ostilhoù evit industriezh an apotikerezh
- Cristec (stroll Enag) – Ijinañ ha fardañ ostilhoù standart evit amdroadur an energiezh
- Cummins Filtration – Fardañ ha skignañ binvioù da silañ evit ar c’hefluskerioù
- Enag – Ijinañ ha fardañ produioù evit amdroadur an energiezh statek ha dinamek
- Génération (stroll Verlingue) – Merañ ar reolioù yec’hed ha ragevezh evit an dud a ra war-dro asuriñ an dud
- Ufast – Chanter-bigi
- Verlingue – Kouratañ asurañsoù war-zu an embregerezhioù
- Yslab – Labourva enklask, ijinañ ha fardañ stignadoù medisinerezh diwar danvezioù eus ar mor hag a c’hall bezañ diouzh ar gwellañ evit ar yec’hed
Da nebeutoc’h eget 50 kilometr
- Bigard - Lazhti
- Hénaff – Boued-mir, charkuterezh industriel
- Capitaine Cook - Boued-mir
- Monique Ranou – Kig-sezon, charkuterezh industriel
- Paul Paulet, Petit navire – Boued-mir
- Chancerelle - Boued-mir
- Bonduelle – Meuzioù fardet
- Tipiak - Meuzioù fardet
- Marie – Charkuterezh, meuzioù fardet enno kig
- Chantier Piriou – Chanter-bigi
- PDM industrie – Industriezh ar c’harton
- Guy Cotten – Dilhad mor
- Mc Bride – Fardañ aerosolioù
Kelaouiñ ac’hanoc’h, sikour ac’hanoc’h : heñchañ an ekonomiezh
Ti-kêr ha Tolpad-kêrioù
44, plasenn Sant-Kaourantin - CS 26004 - 29107 Kemper cedex
Rener : Laurent Bruchon
Sekretouriezh : pgz 02 98 98 87 83 - economie@quimper.bzh




